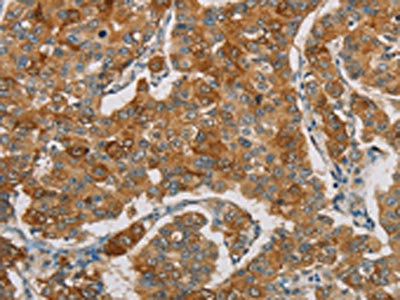

-
中文名稱:FOXF2兔多克隆抗體
-
貨號:CSB-PA027320
-
規(guī)格:¥1100
-
圖片:
-
The image on the left is immunohistochemistry of paraffin-embedded Human cervical cancer tissue using CSB-PA027320(FOXF2 Antibody) at dilution 1/30, on the right is treated with synthetic peptide. (Original magnification: ×200)
-
The image on the left is immunohistochemistry of paraffin-embedded Human breast cancer tissue using CSB-PA027320(FOXF2 Antibody) at dilution 1/30, on the right is treated with synthetic peptide. (Original magnification: ×200)
-
Gel: 8%SDS-PAGE, Lysate: 40 μg, Lane 1-2: Human placenta tissue, human normal liver tissue, Primary antibody: CSB-PA027320(FOXF2 Antibody) at dilution 1/666, Secondary antibody: Goat anti rabbit IgG at 1/8000 dilution, Exposure time: 5 minutes
-
-
其他:
產(chǎn)品詳情
-
Uniprot No.:
-
基因名:FOXF2
-
別名:FOXF2 antibody; FKHL6 antibody; FREAC2Forkhead box protein F2 antibody; Forkhead-related activator 2 antibody; FREAC-2 antibody; Forkhead-related protein FKHL6 antibody; Forkhead-related transcription factor 2 antibody
-
宿主:Rabbit
-
反應(yīng)種屬:Human,Mouse
-
免疫原:Synthetic peptide of Human FOXF2
-
免疫原種屬:Homo sapiens (Human)
-
標(biāo)記方式:Non-conjugated
-
抗體亞型:IgG
-
純化方式:Antigen affinity purification
-
濃度:It differs from different batches. Please contact us to confirm it.
-
保存緩沖液:-20°C, pH7.4 PBS, 0.05% NaN3, 40% Glycerol
-
產(chǎn)品提供形式:Liquid
-
應(yīng)用范圍:ELISA,WB,IHC
-
推薦稀釋比:
Application Recommended Dilution ELISA 1:2000-1:5000 WB 1:500-1:2000 IHC 1:50-1:200 -
Protocols:
-
儲存條件:Upon receipt, store at -20°C or -80°C. Avoid repeated freeze.
-
貨期:Basically, we can dispatch the products out in 1-3 working days after receiving your orders. Delivery time maybe differs from different purchasing way or location, please kindly consult your local distributors for specific delivery time.
-
用途:For Research Use Only. Not for use in diagnostic or therapeutic procedures.
引用文獻(xiàn)
- FOXF2 Regulates PRUNE2 Transcription in the Pathogenesis of Colorectal Cancer T Li,Technology in cancer research & treatment,2022
相關(guān)產(chǎn)品
靶點詳情
-
功能:Probable transcription activator for a number of lung-specific genes. Mediates up-regulation of the E3 ligase IRF2BPL and drives ubiquitination and degradation of CTNNB1.
-
基因功能參考文獻(xiàn):
- FOXF2 rs1711972 AA genotype is associated with poor response to therapy in Non-small Cell Lung Cancer. PMID: 28766235
- miR130a can regulate FOXF2 and function as an oncogene in colorectal cancer. PMID: 28849155
- FOXF2 deficiency induced mesenchymal-epithelial transition (MET) in Huh7 cell which might facilitate the colonization of circulating tumor cells and the formation of metastasis. PMID: 28582850
- Cox proportional hazards regression model was used to evaluate the predictive value of FOXF2 mRNA level in non-small cell lung cancer patients PMID: 27487137
- FOXF2 has a dual role in breast tumorigenesis and functions as either a tumor suppressor or an oncogene depending on the breast tumor subtype. PMID: 27377963
- MAZ/FOXF2 axis can promote the proliferation of basal like breast cancer cells and suppress disease progression. PMID: 28577976
- direct targeting of Foxf2 by Shh signaling drives cranial neural crest cell mesenchyme proliferation during upper lip morphogenesis, and disruption of this sequence results in cleft lip. PMID: 28506991
- Common variants near FOXF2 that are associated with increased stroke susceptibility. PMID: 27068588
- No correlation was found between FOXF2 promoter methylation and other clinic pathological parameters (age, gender, differentiation, lymph node metastasis, stage, cutting edge, vascular invasion, smoking behavior, and drinking history) in esophageal squamous cell carcinoma. PMID: 28222662
- Loss of FOXF2 Expression is associated with Hepatocellular Carcinoma. PMID: 25824262
- results provided statistical evidence of linkage and association between FOXF2 and nonsyndromic cleft lip with or without cleft palate. PMID: 26278207
- The miR-200 family and the miR-183~96~182 cluster target Foxf2 to inhibit invasion and metastasis in lung cancers. PMID: 25798833
- MiR-182-induced downregulation of FoxF2. PMID: 25738520
- Subtype-specific expression and function of FOXF2 in breast cancer cells are regulated through the combined effects of DNA methylation and SP1 transcriptional regulation. PMID: 26070560
- Foxf2 inactivation in adults resulted in blood-brain barrier breakdown, endothelial thickening, and increased trans-endothelial vesicular transport PMID: 26120030
- decreased FOXF2 expression indicates the early-onset metastasis and poor prognosis for patients with histological grade II and triple-negative breast cancer. PMID: 23620774
- MicroRNA-182-5p promotes cell invasion and proliferation by down regulating FOXF2, RECK and MTSS1 genes in human prostate cancer. PMID: 23383207
- 2 unique DNA sequence alterations could have affected FOXF2 on the mRNA or protein level thus contributing to the observed disturbances in genital and palate development PMID: 19276632
- The distinct expression pattern of FOXF2 in the prostate, its effect on expression of signaling, and its opposing role in the TGFbeta3 pathway, suggests a role for FOXF2 in prostate homeostasis and stroma-epithelial interactions PMID: 19562724
顯示更多
收起更多
-
亞細(xì)胞定位:Nucleus.
-
組織特異性:Lung and placenta. Predominantly expressed in gastrointestinal tract including stomach.
-
數(shù)據(jù)庫鏈接:
Most popular with customers
-
-
YWHAB Recombinant Monoclonal Antibody
Applications: ELISA, WB, IHC, IF, FC
Species Reactivity: Human, Mouse, Rat
-
Phospho-YAP1 (S127) Recombinant Monoclonal Antibody
Applications: ELISA, WB, IHC
Species Reactivity: Human
-
-
-
-
-